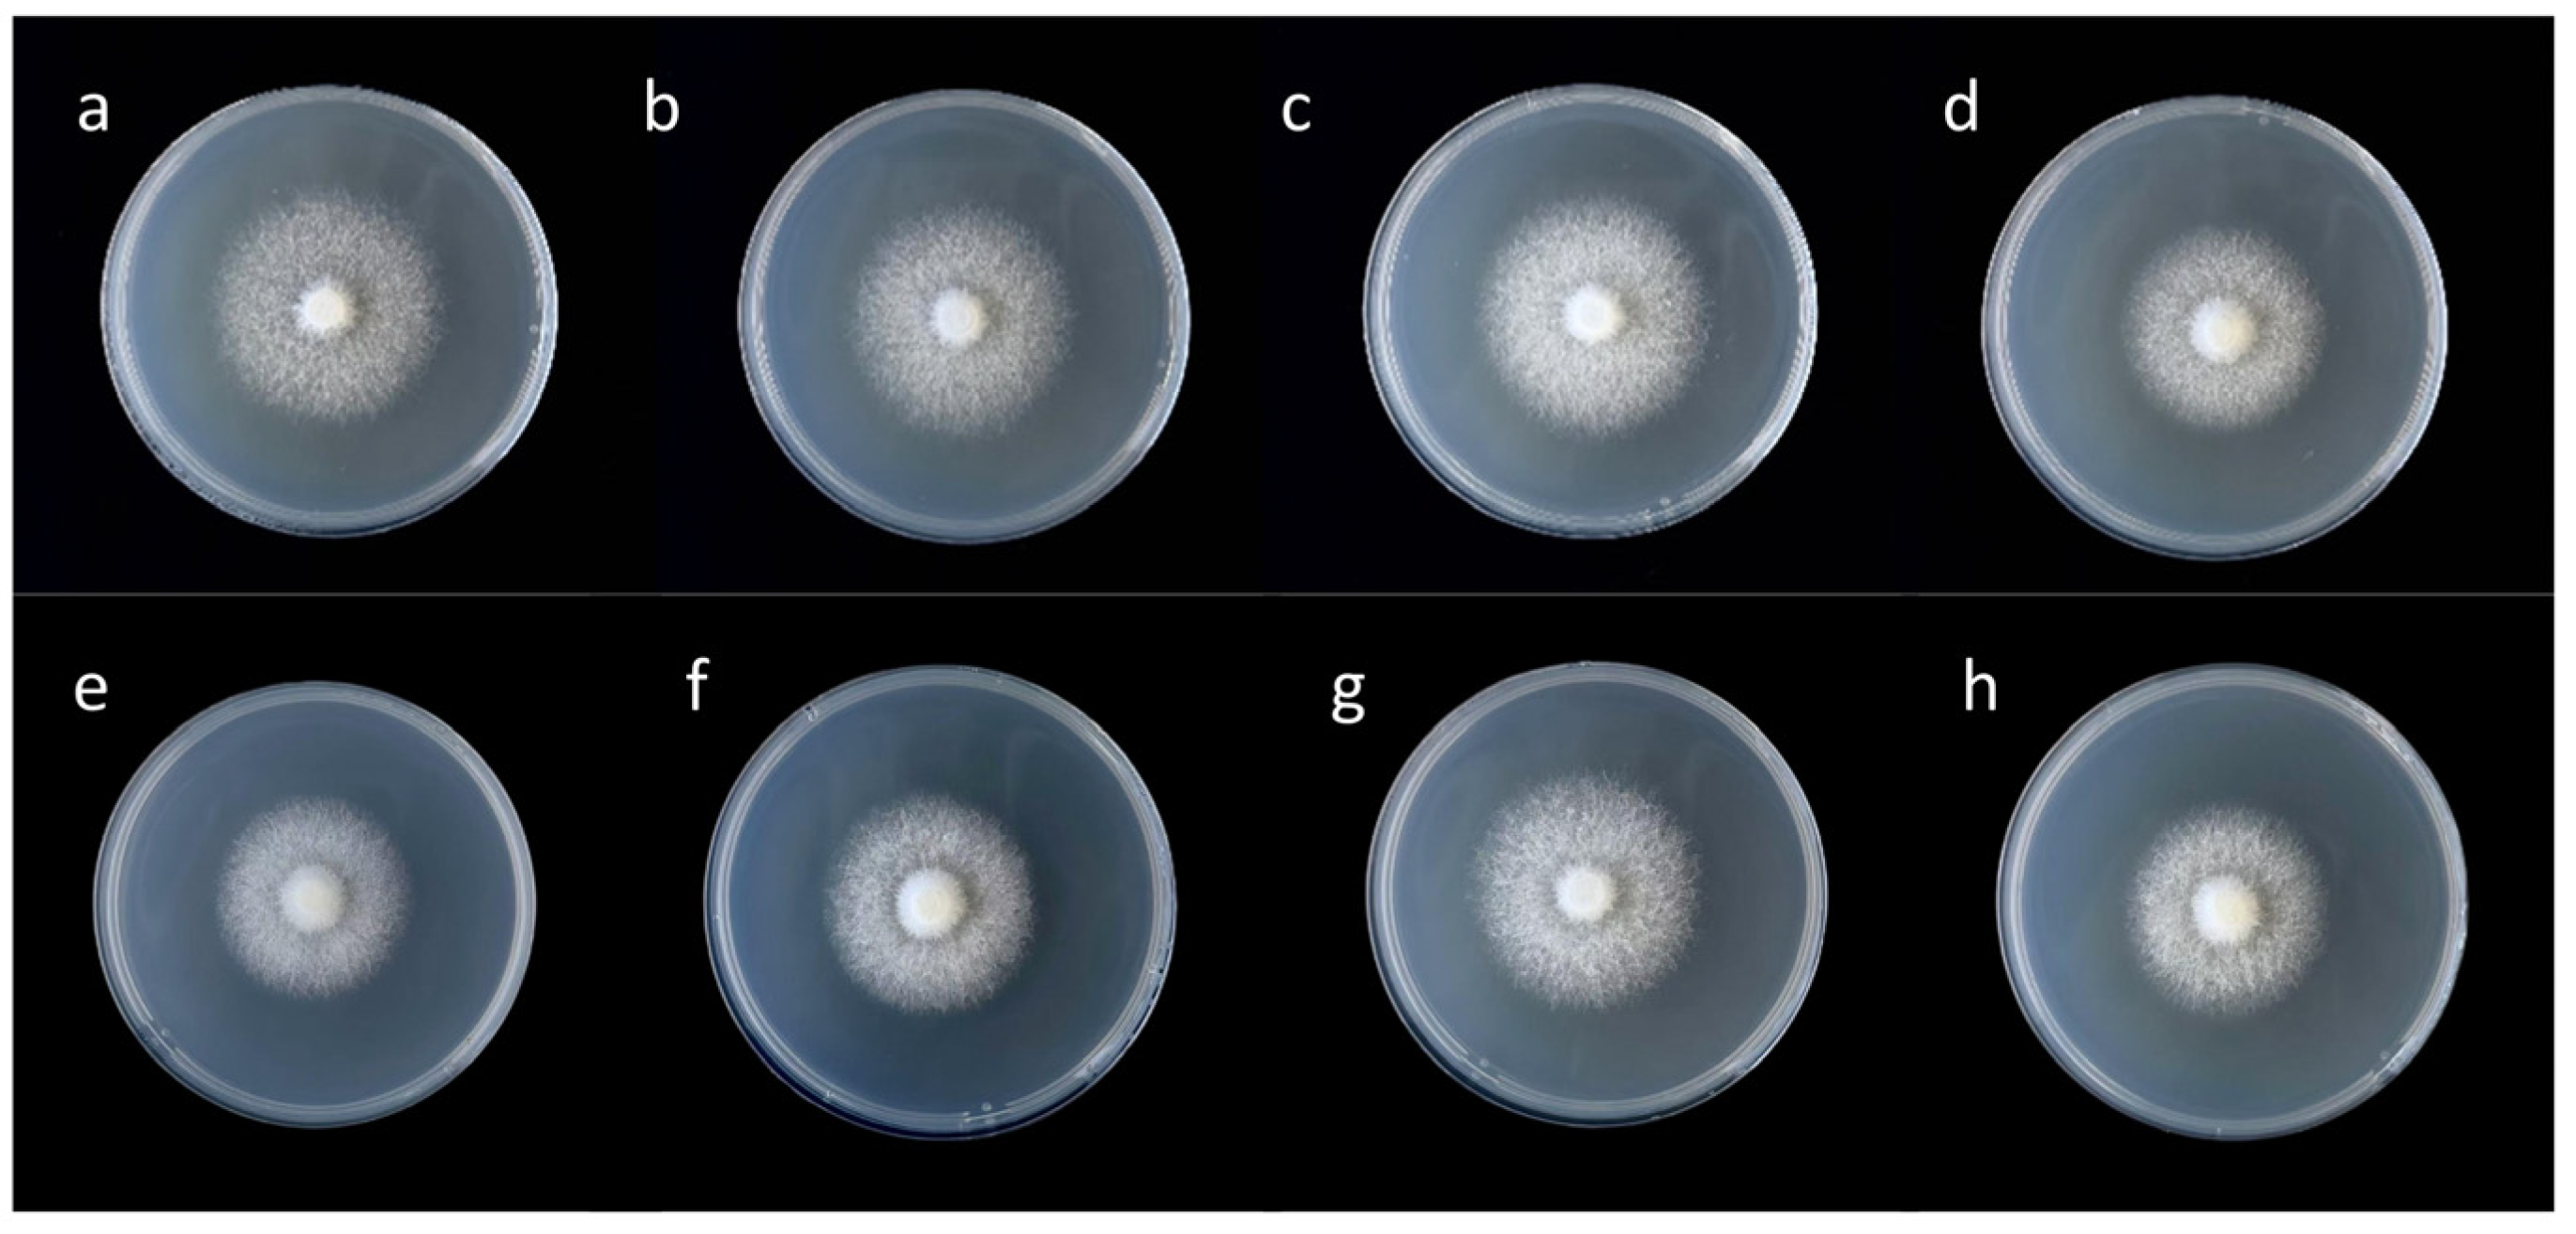
Agronomy 15 01107 g001

Zinc Treatment Effects on the Expression of Enzyme Genes Related to Lysine Synthesis Pathway in Flammulina filiformis Mycelia
Abstract
1. Introduction
2. Materials and Methods
2.1. Materials
2.2. Methods
2.2.1. Experimental Treatment and Strain Culture
2.2.2. Measurement of Mycelium Growth
- Mycelium Growth Rate
- Mycelium Biomass Content
2.2.3. Determination of Zinc Content
2.2.4. Determination of Amino Acids
- Tryptophan Test
- Free Amino Acids Test
2.2.5. Determination of Gene Expression in Lysine Synthesis Pathway
- Extraction of Total RNA and Synthesis of cDNA
- Quantitative Real-Time PCR
- Calculation of Gene Relative Expression
2.2.6. Statistical Analysis
3. Results
3.1. Effects of Different Concentrations of Zn2+ on Mycelia Growth of F. filiformis
3.2. Zinc Content Analysis Under Different Concentrations of Zn2+ Treatment
3.3. Zinc Enrichment Under Different Concentrations of Zn2+ Treatment
3.4. The Contents of Each Amino Acid Under Different Concentrations of Zn2+ Treatment
3.5. Changes in the Lysine and Glutamic Acid Contents Under Different Concentrations of Zn2+ Ttreatment
3.6. Analysis of Key Enzyme Genes in Lysine Synthesis Pathway of F. filiformis Under Different Concentrations of Zn2+ Ttreatment
3.7. Correlation Between Lysine Content and Other Measured Indexes Under Different Concentrations of Zn2+ Treatment
4. Discussion
5. Conclusions
- 1.
- Zn2+ concentration of 30 mg/L resulted in the highest Zinc content in F. filiformis mycelia. At a Zn2+ concentration of 20 mg/L, the growth and the lysine content of the F. filiformis mycelia was the greatest. At this concentration, Zn2+ stimulated the upregulation of HDH and HCD which are key enzyme genes of the lysine synthesis pathway in the F. filiformis mycelia, while the inhibition of AAT made it negatively correlated with the lysine content. Zn2+ synergistically regulated the expression of HDH, HCD, and AAT to affect lysine synthesis in F. filiformis mycelia.
- 2.
- The wild strain FV18 exhibited superior zinc-rich growth characteristics in comparison to the cultivated strain FV8, which could be utilized as a valuable breeding material to develop zinc-rich or high lysine content strains of F. filiformis.
Author Contributions
Funding
Data Availability Statement
Acknowledgments
Conflicts of Interest
References
- Dai, Y.C.; Yang, Z.L. Notes on the nomenclature of five important edible fungi in China. Mycosystema 2018, 37, 1572–1577. [Google Scholar] [CrossRef]
- Vondruška, J.; Šíma, J.; Kobera, M.; Rokos, L.; Šeda, M.; Svoboda, L. Detrimental and essential elements in fruiting bodies of wild-growing fungi Coprinus comatus, Flammulina velutipes, and Armillaria ostoyae. J. Environ. Sci. Health Part B Pestic. Food Contam. Agric. Wastes 2022, 57, 243–251. [Google Scholar] [CrossRef] [PubMed]
- Malinovsky, A.V. Why Threonine Is an Essential Amino Acid in Mammals and Birds: Studies at the Enzyme Level. Biochemistry 2018, 83, 795–799. [Google Scholar] [CrossRef] [PubMed]
- Li, B.; Tan, Y.; Sun, W.; Fu, Y.; Miao, L.; Cai, L. The role of zinc in the prevention of diabetic cardiomyopathy and nephropathy. Toxicol. Mech. Methods 2013, 23, 27–33. [Google Scholar] [CrossRef]
- Khan, S.T.; Malik, A.; Alwarthan, A.; Shaik, M.R. The enormity of the zinc deficiency problem and available solutions; an overview. Arab. J. Chem. 2022, 15, 103668. [Google Scholar] [CrossRef]
- Gupta, S.; Brazier, A.K.M.; Lowe, N.M. Zinc deficiency in low- and middle-income countries: Prevalence and approaches for mitigation. J. Hum. Nutr. Diet. 2020, 33, 624–643. [Google Scholar] [CrossRef]
- Lee, M.-H.; Chao, C.-H.; Hsu, Y.-C.; Lu, M.-K. Production, characterization, and functions of sulfated polysaccharides from zinc sulfate enriched cultivation of Antrodia cinnamomea. Int. J. Biol. Macromol. 2020, 159, 1013–1021. [Google Scholar] [CrossRef]
- Zhang, M.Y.; Hou, M.J.; Shi, H.J.; Jia, L.; Zhang, J.J. Preparation technology and in vitro antioxidant activities of zinc polysaccharides chewable tablets from red flat mushroom (Pleurotus djamor). J. Food Saf. 2022, 42, 108–116. [Google Scholar]
- Li, H.; Shi, L.; Tang, W.; Xia, W.; Zhong, Y.; Xu, X.; Xie, B.; Tao, Y. Comprehensive Genetic Analysis of Monokaryon and Dikaryon Populations Provides Insight Into Cross-Breeding of Flammulina filiformis. Front. Microbiol. 2022, 13, 887259. [Google Scholar] [CrossRef]
- Liu, X.R.; Yang, Z.C.; Xiao, S.X.; Cai, P.; Xie, B.G.; Jiang, Y.J. A New High-yielding Flammulina velutipes Cultivar ‘Nongjin 7’. Acta Hortic. Sin. 2018, 45, 1219–1220. [Google Scholar] [CrossRef]
- Li, Y. The Role of Edible Fungi in Building the Overall Situation of Food Security—Theme Report on Practicing “Big Food Concept” and Exploring the Development Path of Edible Fungi Industry. J. Fungal Res. 2022, 20, 157–159. [Google Scholar] [CrossRef]
- Feng, G.Z.; Shi, H.; Zheng, J.S.; Shi, Y. Research progress of metal ion on the growth and development of edible fungi. Food Res. Dev. 2021, 42, 193–198. [Google Scholar]
- Liu, F.; Pei, F.; Mariga, A.M.; Gao, L.; Chen, G.; Zhao, L. Separation and speciation analysis of zinc from Flammulina velutipes. J. Food Drug Anal. 2015, 23, 630–635. [Google Scholar] [CrossRef] [PubMed]
- Dong, Z.; Xiao, Y.; Wu, H. Selenium accumulation, speciation, and its effect on nutritive value of Flammulina velutipes (Golden needle mushroom). Food Chem. 2021, 350, 128667. [Google Scholar] [CrossRef]
- Hu, T.; Hui, G.; Li, H.; Guo, Y. Selenium biofortification in Hericium erinaceus (Lion’s Mane mushroom) and its in vitro bioaccessibility. Food Chem. 2020, 331, 127287. [Google Scholar] [CrossRef] [PubMed]
- Budzyńska, S.; Siwulski, M.; Gąsecka, M.; Magdziak, Z.; Kalač, P.; Niedzielski, P.; Mleczek, M. Biofortification of Three Cultivated Mushroom Species with Three Iron Salts-Potential for a New Iron-Rich Superfood. Molecules 2022, 27, 2328. [Google Scholar] [CrossRef]
- Hu, Y.J.; Chen, M.F.; Qiang, Y.; Li, H.Y.; Liu, J.; Chen, F.X. Alleviation mechanisms of Zinc-selenium interaction on the cadmiu toxicity in rice under cadmium stress. Biotechnol. Bull. 2022, 38, 143–152. [Google Scholar] [CrossRef]
- Jiang, P.Y.; Shang, X.D.; Song, C.Y.; Wang, R.J.; Yu, H.L.; Li, Q.Z.; Zhang, L.J.; Liu, J.Y.; Tan, Q. Advances in studies on lysine biosynthesis pathway in fungi. Microbiol. China 2020, 47, 915–922. [Google Scholar] [CrossRef]
- Popovic, A.V.; Camagajevac, I.S.; Vukovic, R.; Matic, M.; Velki, M.; Gupta, D.K.; Galic, V.; Loncaric, Z. Biochemical and molecular responses of the ascorbate-glutathione cycle in wheat seedlings exposed to different forms of selenium. Plant Physioology Biochem. 2024, 208, 108460. [Google Scholar] [CrossRef]
- Kobayashi, K.; Nishikawa, M. Promotion of ε-poly-l-lysine production by iron in Kitasatospora kifunense. World J. Microbiol. Biotechnol. 2007, 23, 1033–1036. [Google Scholar] [CrossRef]
- Ekwealor, I.A.; Obeta, J.A.N. Effect of vitamins and bivalent metals on lysine yield in Bacillus megaterium. Afr. J. Biotechnol. 2007, 6, 1348–1351. [Google Scholar]
- Rihacek, M.; Kosaristanova, L.; Fialova, T.; Rypar, T.; Sterbova, D.S.; Adam, V.; Zurek, L.; Cihalova, K. Metabolic adaptations of Escherichia coli to extended zinc exposure: Insights into tricarboxylic acid cycle and trehalose synthesis. BMC Microbiol. 2024, 24, 384. [Google Scholar] [CrossRef] [PubMed]
- Liu, J.Y.; Wang, R.J.; Zhang, D.; Shang, X.D.; Tan, Q. Analysis of genes related to lysine biosynthesis based on whole genome of Flammulina velutipes. Microbiol. China 2016, 43, 2225–2233. [Google Scholar] [CrossRef]
- Tao, Y.X.; Duan, J.Y.; Li, Y.N.; Li, Z.Y.; Song, H.B.; Zhang, Q.S.; Huang, J.H.; Gao, L.L.; Xie, B.G. Identification of genes in Flammulina filiformis L-lysine biosynthesis pathway and their expression in response to light conditions. Acta Edulis Fungi 2018, 25, 1–8. [Google Scholar] [CrossRef]
- Jiang, P.Y.; Shang, X.D.; Song, C.Y.; Xu, Z.; Yu, H.L.; Li, Q.Z.; Zhang, L.J.; Tan, Q.; Wang, R.J.; Liu, J.Y. Effect of low temperature on gene expression in the lysine synthesis pathway of Flammulina filiformis. Acta Edulis Fungi 2020, 27, 24–30. [Google Scholar] [CrossRef]
- Liu, J.Y.; Jiang, P.Y.; Wang, R.J.; Xu, Z.; Zhang, D.; Song, C.Y.; Yu, H.L.; Zhang, L.J.; Zhang, M.Y.; Tan, Q. Effect of α-ketoglutaric Acid on mycelial growth and lysine synthesis of Flammulina filiformis. Acta Edulis Fungi 2019, 26, 10–16. [Google Scholar] [CrossRef]
- Fan, H.; Ge, F.; Wu, T.; Liu, Y.; Tian, L.; Liu, Y.; Xiang, T.; Yu, H.; Shi, L.; He, Q.; et al. The AMP-Activated Protein Kinase (AMPK) Positively Regulates Lysine Biosynthesis Induced by Citric Acid in Flammulina filiformis. J. Fungi 2023, 9, 340. [Google Scholar] [CrossRef]
- Xu, Z.; Zhang, L.J.; Shang, X.D.; Liu, J.Y.; Zhang, D.; Yang, H.; Yu, H.L.; Zhang, M.Y.; Wang, R.J. Gradation and evaluation for Flammulina filiformis DUS testing traits. Mycosystema 2019, 38, 658–668. [Google Scholar] [CrossRef]
- GB 5009.268-2016, 20; National Standard for Food Safety Determination of Various Elements in Food. China Food and Drug Administration: Beijing, China, 2016.
- GB 5009.124-2016, 12; National Standard for Food Safety Determination of Amino Acids in Foods. China Food and Drug Administration: Beijing, China, 2016.
- Lin, H.; Yu, X.; Fang, J.; Lu, Y.; Liu, P.; Xing, Y.; Wang, Q.; Che, Z.; He, Q. Flavor Compounds in Pixian Broad-Bean Paste: Non-Volatile Organic Acids and Amino Acids. Molecules 2018, 23, 1299. [Google Scholar] [CrossRef]
- Luo, S.Y.; Liang, Y.Q.; Chen, B.S.; Lin, M.T.; Liang, J.X.; Qiu, J.K. Accumulation and Migration of Heavy Metals in Mangrove Sediments and Plants in the Nanshan Town, Xuwen. Trop. Geogr. 2019, 39, 347–356. [Google Scholar] [CrossRef]
- Trumbo, P.; Schlicker, S.; Yates, A.A.; Poos, M. Dietary reference intakes for energy, carbohydrate, fiber, fat, fatty acids, cholesterol, protein and amino acids. J. Am. Diet. Assoc. 2002, 102, 1621–1630. [Google Scholar] [CrossRef]
- Robinson, J.R.; Isikhuemhen, O.S.; Anike, F.N. Fungal-Metal Interactions: A Review of Toxicity and Homeostasis. J. Fungi 2021, 7, 225. [Google Scholar] [CrossRef] [PubMed]
- Oliveira, A.P.d.; Naozuka, J. Preliminary results on the feasibility of producing selenium-enriched pink (Pleurotus djamor) and white (Pleurotus ostreatus) oyster mushrooms: Bioaccumulation, bioaccessibility, and Se-proteins distribution. Microchem. J. 2019, 145, 1143–1150. [Google Scholar] [CrossRef]
- de Oliveira, A.P.; Naozuka, J.; Landero-Figueroa, J.A. Effects of Se(IV) or Se(VI) enrichment on proteins and protein-bound Se distribution and Se bioaccessibility in oyster mushrooms. Food Chem. 2022, 383, 132582. [Google Scholar] [CrossRef] [PubMed]
- Wang, Y.; Miao, M.; Fang, H.; Zheng, Y.; Liu, L.; Gu, X.; Xu, X.; Liu, X.; Tang, Y.; Lai, Q.; et al. Physiological and metabolomic insights into molecular mechanisms of root sensitivity to zinc toxicity in rice (Oryza sativa L.). J. Hazard. Mater. 2025, 492, 138204. [Google Scholar] [CrossRef]
- Zhou, Y.; Nie, K.; Geng, L.; Wang, Y.; Li, L.; Cheng, H. Selenium’s Role in Plant Secondary Metabolism: Regulation and Mechanistic Insights. Agronomy 2025, 15, 54. [Google Scholar] [CrossRef]
- Zhang, Z.; Li, L.; Qiu, S.; Sun, Y.; Zhang, R.; Chen, D.; Chen, P.; Song, Y.; Zeng, R.; Lu, L. BAHD acyltransferase OsSLG mediates rice cadmium tolerance by integrating the brassinosteroid and salicylic acid pathway. Plant Sci. 2025, 356, 112503. [Google Scholar] [CrossRef]
- Liu, J.Y.; Chang, M.C.; Meng, J.L.; Feng, C.P.; Wang, Y. A Comparative Proteome Approach Reveals Metabolic Changes Associated with Flammulina velutipes Mycelia in Response to Cold and Light Stress. J. Agric. Food Chem. 2018, 66, 3716–3725. [Google Scholar] [CrossRef]
- Liu, F.; Wang, W.; Chen, B.Z.; Xie, B.G. Homocitrate synthase expression and lysine content in fruiting body of different developmental stages in Flammulina velutipes. Curr. Microbiol. 2015, 70, 821–828. [Google Scholar] [CrossRef]
- Liu, J.; Li, Q.; Jiang, P.; Xu, Z.; Zhang, D.; Zhang, L.; Zhang, M.; Yu, H.; Song, C.; Tan, Q.; et al. Overexpression of the saccharopine dehydrogenase gene improves lysine biosynthesis in Flammulina velutipes. J. Basic Microbiol. 2019, 59, 890–900. [Google Scholar] [CrossRef]
- Yang, H.; Zhang, M.Y.; Song, C.Y.; Liu, J.Y.; Xu, Z.; Shang, X.D. Effects of Fe2+, Zn2+ and Ca2+ on mycelium growth and its biological enrichment in mycelia of three edible mushroom. Acta Edulis Fungi 2017, 24, 27–33. [Google Scholar] [CrossRef]
- Lanfranco, L.; Balsamo, R.; Martino, E.; Perotto, S.; Bonfante, P. Zinc ions alter morphology and chitin deposition in an ericoid fungus. Eur. J. Histochem. 2002, 46, 341–350. [Google Scholar] [CrossRef] [PubMed]
- Kapoor, A.; Viraraghavan, T. Fungal biosorption—An alternative treatment option for heavy metal bearing wastewaters: A review. Bioresour. Technol. 1995, 53, 195–206. [Google Scholar] [CrossRef]
- Fomina, M.; Gadd, G.M. Biosorption: Current perspectives on concept, definition and application. Bioresour. Technol. 2014, 160, 3–14. [Google Scholar] [CrossRef]
- Gadd, G.M. Metals, minerals and microbes: Geomicrobiology and bioremediation. Microbiology 2010, 156, 609–643. [Google Scholar] [CrossRef] [PubMed]
- Zhao, H.; Eide, D. The ZRT2 Gene Encodes the Low Affinity Zinc Transporter in Saccharomyces cerevisiae. J. Biol. Chem. 1996, 271, 23203–23210. [Google Scholar] [CrossRef]
- Ramezannejad, R.; Pourianfar, H.R.; Rezaeian, S. Interactive Effects of Selenium, Zinc, and Iron on the Uptake of Selenium in Mycelia of the Culinary-Medicinal Winter Mushroom Flammulina velutipes (Agaricomycetes). Int. J. Med. Mushrooms 2023, 25, 75–87. [Google Scholar] [CrossRef]
- Igamberdiev, A.U.; Eprintsev, A.T. Organic Acids: The Pools of Fixed Carbon Involved in Redox Regulation and Energy Balance in Higher Plants. Front. Plant Sci. 2016, 7, 1042. [Google Scholar] [CrossRef]
- Wang, J.; Chen, C. Biosorption of heavy metals by Saccharomyces cerevisiae: A review. Biotechnol. Adv. 2006, 24, 427–451. [Google Scholar] [CrossRef]
- Ehmann, D.E.; Gehring, A.M.; Walsh, C.T. Lysine biosynthesis in Saccharomyces cerevisiae: Mechanism of alpha-aminoadipate reductase (Lys2) involves posttranslational phosphopantetheinylation by Lys5. Biochemistry 1999, 38, 6171–6177. [Google Scholar] [CrossRef]
- Hogg, R.W.; Broquist, H.P. Homocitrate Formation in Neurospora crassa: Relation to lysine biosynthesis. J. Biol. Chem. 1968, 243, 1839–1845. [Google Scholar] [CrossRef] [PubMed]
- Brown, A.M.; Kristal, B.S.; Effron, M.S.; Shestopalov, A.I.; Ullucci, P.A.; Sheu, K.F.R.; Blass, J.P.; Cooper, A.J.L. Zn2+ Inhibits α-Ketoglutarate-stimulated Mitochondrial Respiration and the Isolated α-Ketoglutarate Dehydrogenase Complex. J. Biol. Chem. 2000, 275, 13441–13447. [Google Scholar] [CrossRef] [PubMed]
- Chen, Y.; Ju, H.; Li, H.; Xu, C.; Jia, H.; Xian, L.; Yuan, C.; Guo, Z.; Zhang, X.; Yu, Y.; et al. Light and phytochrome PHY control the production of edible fungus Flammulina filiformis by regulating the morphogenesis of fruiting bodies and l-lysine accumulation. J. Photochem. Photobiol. B Biol. 2024, 261, 113051. [Google Scholar] [CrossRef] [PubMed]

| Group | CK | I | II | III |
|---|---|---|---|---|
| Concentrations of Zn2+ (mg/L) | 0 | 10 | 20 | 30 |
| ZnSO4·7H2O (ml/L) | 0 | 0.5 | 1 | 1.5 |
| Gene ID | Forward Primer (5’-3’) | Reverse Primer (5’-3’) |
|---|---|---|
| HCS | TCACACACAAGGCAGGTATTC | CATATCGCGTGAGACCAAAGT |
| HCD | TCCAAGGCTGGTGCTATTG | CCGGATACAAACATGGGTATGA |
| HAH | CGCCCTCTTTGGTTCAGTTA | TCGGACATTCCCGTAGAGAT |
| SDH | GGCTTCAGATTCAGGCTATCA | GAGTGGAGTCACCAGTCTTTC |
| AAR | CAGACGTGATAAGGACGAAGAG | TCTTTGATAAGGCGACGATACTT |
| AAT | CGAGCAAGAATCCAAACCTCT | CGCAACCCACAAGTTCATTTC |
| HDH | AACGGGCGTCAAGAAGAATAG | CCTACCGAACGAACAGTTTCTC |
| SR | GAGATCCTGAGTGGCCATTATC | GGTATCTTCCGTGGTGGAATAG |
| SPRYp | CACAGTAATATCTCCAGACGCG | TCCTACCACTCCTTCGCCTGTTG |
| Concentrations of Zn2+ (mg/L) | Group | |||
|---|---|---|---|---|
| FV8 | FV18 | |||
| Mycelia Growth Rate (mm/d) | Mycelia Biomass (g) | Mycelia Growth Rate (mm/d) | Mycelia Biomass (g) | |
| 0 | 9.255 ± 0.206 bc | 0.050 ± 0.002 a | 9.105 ± 0.138 c | 0.071 ± 0.004 b |
| 10 | 9.540 ± 0.083 b | 0.053 ± 0.003 a | 9.527 ± 0.090 b | 0.077 ± 0.006 ab |
| 20 | 10.007 ± 0.163 a | 0.056 ± 0.006 a | 10.137 ± 0.180 a | 0.082 ± 0.006 a |
| 30 | 9.038 ± 0.239 c | 0.037 ± 0.001 b | 8.910 ± 0.157 c | 0.057 ± 0.003 c |
| Concentrations of Zn2+ (mg/L) | Zinc Enrichment Rate per Unit Mass of Mycelia (100%) | Zinc Enrichment Rate Under Total Mycelia (100%) | ||
|---|---|---|---|---|
| FV8 | FV18 | FV8 | FV18 | |
| 10 | 1.207 ± 0.188 b | 1.453 ± 1.058 a | 0.338 ± 0.045 a | 0.589 ± 0.065 a |
| 20 | 1.243 ± 0.172 b | 1.487 ± 0.330 a | 0.429 ± 0.074 a | 0.672 ± 0.018 a |
| 30 | 1.69 ± 0.197 a | 2.253 ± 0.451 a | 0.386 ± 0.066 a | 0.564 ± 0.061 a |
Disclaimer/Publisher’s Note: The statements, opinions and data contained in all publications are solely those of the individual author(s) and contributor(s) and not of MDPI and/or the editor(s). MDPI and/or the editor(s) disclaim responsibility for any injury to people or property resulting from any ideas, methods, instructions or products referred to in the content. |
© 2025 by the authors. Licensee MDPI, Basel, Switzerland. This article is an open access article distributed under the terms and conditions of the Creative Commons Attribution (CC BY) license (https://creativecommons.org/licenses/by/4.0/).
Share and Cite
Qu, Y.; Yao, F.; Lu, L.; Shan, X.; Qu, S. Zinc Treatment Effects on the Expression of Enzyme Genes Related to Lysine Synthesis Pathway in Flammulina filiformis Mycelia. Agronomy 2025, 15, 1107. https://doi.org/10.3390/agronomy15051107
Qu Y, Yao F, Lu L, Shan X, Qu S. Zinc Treatment Effects on the Expression of Enzyme Genes Related to Lysine Synthesis Pathway in Flammulina filiformis Mycelia. Agronomy. 2025; 15(5):1107. https://doi.org/10.3390/agronomy15051107
Chicago/Turabian StyleQu, Yu, Fangjie Yao, Lixin Lu, Xianqi Shan, and Shengtao Qu. 2025. "Zinc Treatment Effects on the Expression of Enzyme Genes Related to Lysine Synthesis Pathway in Flammulina filiformis Mycelia" Agronomy 15, no. 5: 1107. https://doi.org/10.3390/agronomy15051107
APA StyleQu, Y., Yao, F., Lu, L., Shan, X., & Qu, S. (2025). Zinc Treatment Effects on the Expression of Enzyme Genes Related to Lysine Synthesis Pathway in Flammulina filiformis Mycelia. Agronomy, 15(5), 1107. https://doi.org/10.3390/agronomy15051107
